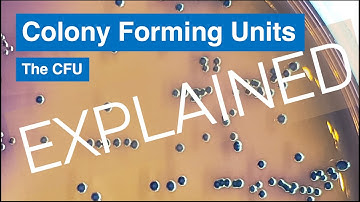
From One Cell to Billions - Colony Forming Units

⬇ DOWNLOAD NOW
Kalau muncul iklan pop-up, tutup lalu klik tombol kembali
Download lagu Procedure for Setting Up the CFU Assay secara gratis hanya untuk keperluan promosi. Dukung artis favorit kamu dengan membeli musik original di iTunes atau platform resmi lainnya.
 How to Set Up Hematopoietic Colony-Forming Unit (CFU) Assays
How to Set Up Hematopoietic Colony-Forming Unit (CFU) Assays
 CFU Assay Set Up for Custom Hematopoietic Training Courses
CFU Assay Set Up for Custom Hematopoietic Training Courses
 How to Set Up the CFU Assay for Custom Hematopoietic Training Courses Using SmartDish™
How to Set Up the CFU Assay for Custom Hematopoietic Training Courses Using SmartDish™
 Implementing the CFU Assay As a Potency Assay for Hematopoietic Cell Therapy Products
Implementing the CFU Assay As a Potency Assay for Hematopoietic Cell Therapy Products
 Colony-Forming Cell (CFC) or Colony-Forming Unit (CFU) Assays: The Basics
Colony-Forming Cell (CFC) or Colony-Forming Unit (CFU) Assays: The Basics
From One Cell to Billions - Colony Forming Units
From One Cell to Billions - Colony Forming Units
 CAMEO-96: A Standardized Methylcellulose CFU Proliferation and Differentiation Assay
CAMEO-96: A Standardized Methylcellulose CFU Proliferation and Differentiation Assay
 How to Standardize and Automate Hematopoietic Colony Counting in CFU Assays with STEMvision™
How to Standardize and Automate Hematopoietic Colony Counting in CFU Assays with STEMvision™